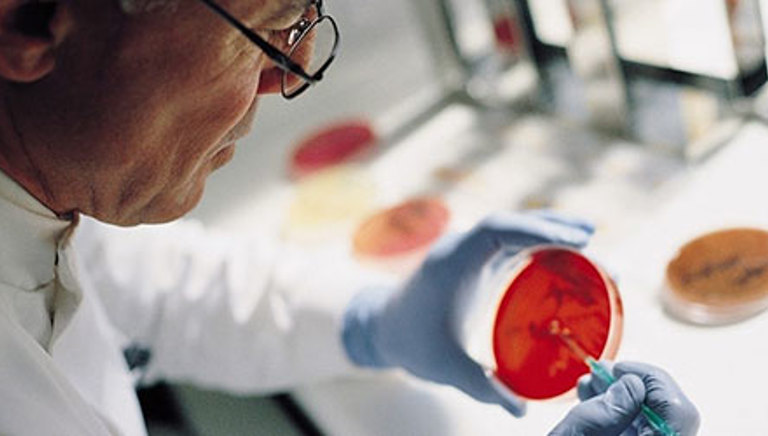

Celebrating UK progress in tackling the global threat of antimicrobial resistance (AMR)
Blog by Amit Aggarwal, ABPI Executive Director, Medical Affairs and Strategic Partnerships
Today marks the start of World Antimicrobial Awareness Week, and it is a time to reflect that our fight against antimicrobial resistance (AMR) has only just begun.
AMR continues to pose a severe threat to modern healthcare, making infections harder to treat and putting our lives at risk. But reasons for hope exist. Over the past year, all four nations of the UK, and the broader global community, have made meaningful progress.
Let’s reflect on what has been achieved since last November and what the focus needs to be for the year ahead.
What is AMR?
Before I start, I think it’s worth recapping what AMR is and why the work of the UK is so important.
Antibiotics and antifungals are the cornerstone of modern medicine. Not only are they pivotal in the treatment of common infections that were once fatal, but they are also essential supporting therapies for many routine healthcare procedures and treatments – such as major surgery (i.e. joint replacements, transplantation[i]), caesarean sections[ii] and cancer chemotherapy[iii].
Resistance to these medicines occurs naturally, but overuse over decades has contributed to an acceleration in the development of resistance in some bacteria and fungi, resulting in infections that are no longer treatable. This is known as “antimicrobial resistance” or AMR[iv]
The number of antimicrobial-resistant bacteria is on the rise across the globe, and it is predicted that they will cause 10 million deaths per year worldwide by 2050[v].
There are two key elements to tackling AMR: the first is better stewardship of the existing antibiotics that we have; and the second is developing new, effective medicines and vaccines that work against resistant bacteria.
Antibiotics are where our industry has focused our attention because, despite the need, there are too few new antibiotics in development. As of 2021, there were only 43 new antimicrobials in clinical trials[vi], compared, for example, to about 1,800 immuno-oncology drugs in 2020[vii].
So, what is happening to address this challenge?
Launch of the UK’s National Action Plan 2024-2029
Back in May, the UK launched its second five-year National Action Plan (NAP) on AMR covering 2024-2029. This was an essential step in renewing the country’s 20-year vision to control and mitigate AMR by 2040.
The UK plan has been developed in a collaboration between the governments of the UK and adopts the “One Health” approach which considers human health, animals, food, and environmental factors as interconnected parts of the AMR picture. We are proud to support this renewed commitment and support the plan’s continued focus on innovation and responsible antibiotic use.
As the UK progresses with the plan, we’d like to see monitoring to assess the plan’s impact and sustained funding to ensure it remains on track. We would also like to see greater recognition of the role of vaccines, which are an essential tool in reducing infection rates and antibiotic dependency.
Collaborative efforts across the UK to launch an innovative payment model for new antibiotics
One of the UK’s standout developments in the fight against AMR is the subscription-style payment model for antibiotics. Designed to incentivise the development of much needed new antibiotics, the model ensures that companies are rewarded for their innovations without the pressure to sell large quantities, encouraging the responsible use of these lifesaving treatments.
The model was formally launched this summer, and the next stage will be in November next year where we expect to see which antibiotics the UK has decided to purchase. In the future, each nation of the UK will have a choice of which antibiotics and how many they want to buy. It is brilliant that this has been a cross-UK effort so far, and we look forward to seeing how this progresses and the impact it has on patients when they can access new lifesaving antibiotics.
For this model to reach its full potential, other countries must follow the UK in providing pull incentives to develop and launch new antibiotics. The UK cannot tackle the AMR crisis in isolation. The international community now has a significant role to play in implementing incentives for antibiotic innovation and boosting global investment in new antibiotics.
Political Declaration on AMR at this year’s UN General Assembly
September brought a significant moment for AMR on the world stage. During the United Nations General Assembly (UNGA), world leaders met to discuss and agree on a landmark political declaration on AMR.
The declaration, supported by the UK, calls for an urgent, coordinated global response to AMR. It calls on all member states to align their AMR strategies with the World Health Organization’s guidelines.
The UK played a leading role in advocating for this moment by sharing learnings from national efforts in the hope of inspiring other nations to take decisive action against AMR.
The use of vaccines as a critical tool against AMR
October saw the release of an important report from the World Health Organization (WHO) on the role of vaccines in reducing AMR. The findings showed that vaccination prevents infections, reduces pathogen transmission and limits antibiotic reliance.
In 2019 alone, an estimated five million people lost their lives due to drug-resistant infections. The WHO estimates that widespread vaccine use could prevent over 500,000 deaths annually by reducing the need for antibiotics. Improving coverage of AMR-relevant vaccinations both in the UK and globally would make an enormous difference.
The UK was one of the first countries to recognise the role of vaccination in reducing AMR. We are pushing for AMR impact assessments to form part of the decision-making on what vaccinations are offered by the NHS. This is significant as there are 15 vaccine candidates in development that specifically target antibiotic-resistant bacteria on the WHO’s Priority Pathogens list.
Continuing the momentum and inspiring global action
Another major asset will be the opening of the Fleming Centre in years to come. Chaired by Professor Lord Darzi, the Fleming Centre will combine cutting edge research, public engagement, and work with policymakers to drive a global change.
The UK’s leadership in tackling AMR should be celebrated, but the fight against AMR is far from over. AMR demands continued investment, collaboration, and innovation to achieve the UK’s 20-year vision.
Success relies on industry, policymakers, healthcare professionals, and the public remaining engaged and committed to turning the tide on AMR – both in the UK and globally.
As we reflect on the milestones of the past year, we need to remain vigilant in our efforts.
Global action is the only way to secure a future where AMR is contained and controlled. In 2025, we want to see other countries begin to introduce innovative payment models to drive greater investment in antibiotics. In doing, we will unlock further innovation in antibiotics and vaccines and reduce the impact of AMR for future generations.
[ii] Caesarean section - Risks - NHS (www.nhs.uk)
[iii] ReAct Policy Brief: Successful cancer treatment relies on effective antibiotics
[iv] O'Neill, The Review on Antimicrobial Resistance, 2016
[v] New report calls for urgent action to avert antimicrobial resistance crisis
- AMR
- Anti Microbial Resistance
- Antibiotic resistance
- Antibiotics
Last modified: 22 November 2024
Last reviewed: 22 November 2024